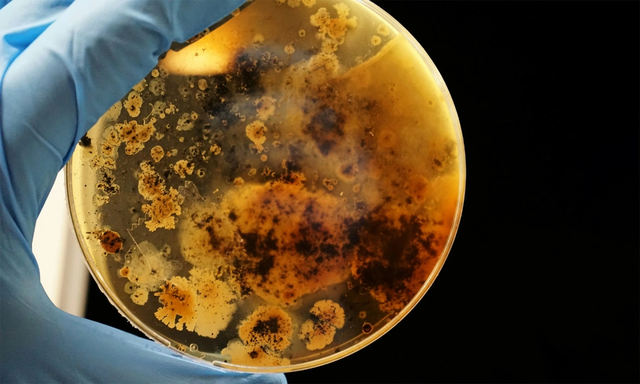
"Báu vật khác thường" tại mỏ đất hiếm lớn nhất thế giới: Có thể thay đổi tương lai nhân loại saarvienin a 1747626287881258566225 1747712997658 1747712997906866191108

Đây là thông tin mới nhất đăng trên tạp chí Angewandte Chemie International Edition của Hiệp hội Hóa học Đức (GDCh).
Kháng sinh mới saarvienin A có thể chống lại siêu vi khuẩn
Một nhóm các nhà khoa học Đức và Áo đã phát hiện ra một phân tử mới có sức mạnh kháng sinh đáng gờm, có thể chống lại siêu vi khuẩn bên trong một mỏ đất hiếm lớn nhất thế giới ở Trung Quốc.
Kháng sinh đó là saarvienin A, một loại kháng sinh glycopeptide hoàn toàn mới được sản xuất bởi một chủng vi khuẩn Amycolatopsis khác thường – một chi vi khuẩn được biết đến với khả năng tạo ra những loại thuốc mạnh như vancomycin.
Hình ảnh các cụm vi khuẩn phát triển trên đĩa thí nghiệm kết hợp với bột sắt. Ảnh: Adrian Lange/Bapt
Các nhà khoa học từ Đại học Vienna (Áo) và Viện nghiên cứu dược phẩm Helmholtz Saarland (Đức) đã nuôi cấy vi khuẩn trong phòng thí nghiệm và chiết xuất các hợp chất tự nhiên của chúng. Trong số đó có saarvienin A, được phát hiện có hoạt tính mạnh chống lại vi khuẩn Gram dương, đặc biệt là các chủng tụ cầu vàng Staphylococcus aureus kháng với các loại kháng sinh thông thường như methicillin, vancomycin và daptomycin.
Saarvienin A hoạt động theo một cách độc đáo. Trong khi hầu hết các loại kháng sinh glycopeptide như vancomycin nhắm vào quá trình tổng hợp thành tế bào vi khuẩn bằng cách liên kết với các khối xây dựng cụ thể, thì saarvienin A dường như hoạt động thông qua một cơ chế vẫn chưa được hiểu đầy đủ. Nó cũng có một cấu trúc hấp dẫn, khác biệt đáng kể so với các loại glycopeptide họ hàng của nó.
“Chúng tôi rất vui mừng khi phát hiện ra rằng saarvienin A không phù hợp với bất kỳ danh mục nào đã biết. Cấu trúc độc đáo của nó có thể mở đường cho các loại kháng sinh mà vi khuẩn chưa từng gặp trước đây” – Jaime Felipe Guerrero-Garzón, tác giả nghiên cứu từ Khoa Khoa học Dược phẩm của Đại học Vienna (Áo), cho biết trong một tuyên bố.

Một chủng Acinetobacter baumannii kháng thuốc cao, chủ yếu thuộc dòng GC2 chiếm ưu thế toàn cầu. Ảnh: Scitechdaily
Nhìn về phía trước, nhóm nghiên cứu muốn đào sâu hơn vào hợp chất mới này và kiểm tra xem liệu nó có tiềm năng trở thành ứng cử viên thuốc cho con người hay không.
“Việc phát hiện ra một loại kháng sinh mới chỉ là bước khởi đầu. Bây giờ chúng ta phải đối mặt với thách thức hấp dẫn là tinh chế nó thành “ứng viên” thuốc phù hợp để sử dụng lâm sàng”, tác giả Sergey B. Zotchev từ Đại học Vienna cho biết.
Loài người đang rất cần loại kháng sinh mới
IFLscience bình luận, loài người đang rất cần loại kháng sinh mới do tình trạng kháng thuốc kháng sinh gia tăng trên thế giới. Việc lạm dụng và sử dụng sai thuốc kháng sinh truyền thống đã khiến một số vi khuẩn phát triển đột biến kháng thuốc đối với thuốc thông thường, tạo ra các bệnh nhiễm trùng cực kỳ khó điều trị.
Theo báo cáo trên tạp chí y khoa Lancet (Anh) năm 2022, vi khuẩn kháng thuốc đã gây ra 1,27 triệu ca tử vong trên toàn cầu vào năm 2019, nhưng con số này dự kiến sẽ tăng lên 8,22 triệu ca tử vong mỗi năm vào năm 2050.
May mắn thay, các hợp chất kháng khuẩn mới vẫn đang được phát hiện. Một số được tìm thấy trong tự nhiên – ẩn trong đất, lỗ thông thủy nhiệt dưới biển sâu hoặc thậm chí là trong các mỏ – trong khi những hợp chất khác đang được phát hiện với sự trợ giúp của trí tuệ nhân tạo (AI).
Các nhà khoa học hiện đang sử dụng AI để sàng lọc qua các thư viện kỹ thuật số khổng lồ về các hợp chất hóa học, xác định chính xác những hợp chất có khả năng tiêu diệt siêu vi khuẩn kháng thuốc. Cho đến nay, nó đang chứng minh là một thành công đáng kinh ngạc, mở ra tương lai mới cho nhân loại trong việc chống lại các vi khuẩn kháng thuốc.
Chủng vi khuẩn độc đáo này được phát hiện tại Khu khai thác Bayan Obo thuộc Khu tự trị Nội Mông (Trung Quốc) rộng 48km2, nơi có các mỏ nguyên tố đất hiếm lớn nhất được biết đến trên Trái đất. Mỏ này nổi tiếng với trữ lượng quặng sắt và nguyên tố đất hiếm đáng kể của thế giới.

Ảnh chụp từ trên không của mỏ Bayan Obo. Nguồn: Getty Images
Mỏ Bayan Obo ước tính chứa hơn 100 triệu tấn trữ lượng đất hiếm đã được chứng minh. Các trữ lượng này chiếm hơn 80% tổng trữ lượng đất hiếm của Trung Quốc và là một trong những trữ lượng lớn nhất thế giới. Mỏ cũng là nguồn cung cấp sắt, niobi và fluorit đáng kể.
Năm 2023, tại mỏ Bayan Obo người ta cũng phát hiện một loại quặng mới, được gọi là niobobaotite, và chứa nguyên tố đất hiếm niobi — một kim loại có giá trị hoạt động như một chất siêu dẫn và có thể cách mạng hóa công nghệ pin.
Ngoài quặng sắt, mỏ lộ thiên khổng lồ này còn sản xuất 15 loại khoáng chất đất hiếm được sử dụng trong nhiều lĩnh vực khác nhau, bao gồm lọc dầu, nam châm vĩnh cửu, công nghệ năng lượng tái tạo, cũng như trong các ứng dụng luyện kim, đánh bóng và quốc phòng.
(Theo IFLscience, NSenergybusiness)







